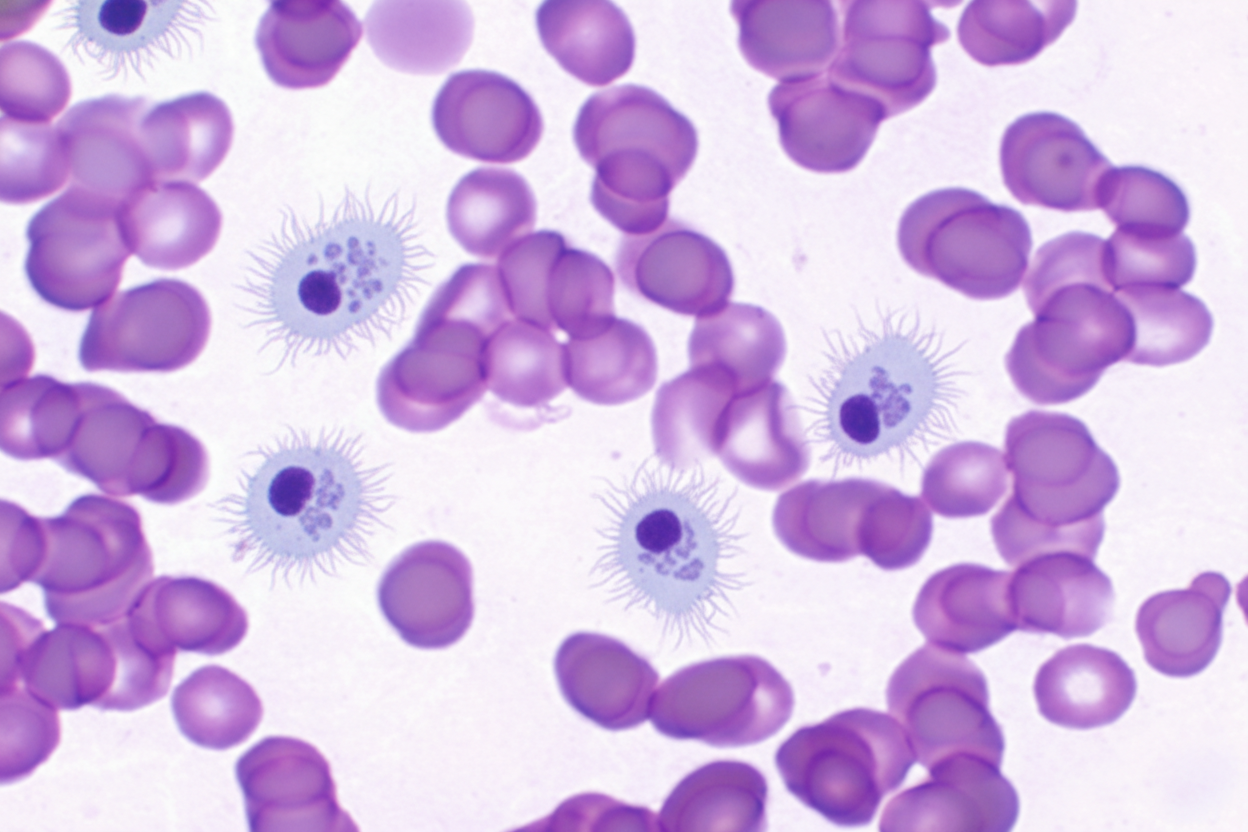
Image for question 73

A 34-year-old woman visits an outpatient clinic with a complaint of pain in her left breast for the last few months. The pain worsens during her menstrual cycle and relieves once the cycle is over. She denies any nipple discharge, skins changes, warmth, erythema, or a palpable mass in the breast. Her family history is negative for breast, endometrial, and ovarian cancer. There is no palpable mass or any abnormality in the physical examination of her breast. A mammogram is ordered which shows a cluster of microcalcifications with a radiolucent center. A breast biopsy is also performed which reveals a lobulocentric proliferation of epithelium and myoepithelium. Which of the following is the most likely diagnosis?
A 65-year-old man comes to the physician because he is worried about a mole on his right forearm. He has had the mole for several years, but it has grown in size in the past 3 months. Physical examination shows a hyperpigmented plaque with irregular borders and small area of ulceration. Histopathologic analysis of a full-thickness excisional biopsy confirms the diagnosis of malignant melanoma. Invasion of which of the following layers of skin carries the highest risk of mortality for this patient?
An 11-year-old boy who recently emigrated from Nigeria is brought to the physician for evaluation of jaw swelling. He has no history of serious illness and takes no medications. Examination shows a 5-cm solid mass located above the right mandible and significant cervical lymphadenopathy. A biopsy specimen of the mass shows sheets of lymphocytes with interspersed tingible body macrophages. Serology for Epstein-Barr virus is positive. Which of the following chromosomal translocations is most likely present in cells obtained from the tissue mass?
An 11-year-old boy presents to your clinic after 4 months of pain and swelling in his thigh. His mother states that at first she thought his condition was due to roughhousing, but it hasn’t gone away and now she’s concerned. You perform an X-ray that shows an ‘onion skin’ appearance on the diaphysis of the femur. You are concerned about a malignancy, so you perform a PET scan that reveals lung nodules. Which of the following is most associated with this disease?
A 40-year-old chronic smoker presents to the office complaining of a cough and pleuritic chest pain. He also has had pain in his right shoulder for the past 2 weeks. He denies fever, night sweats, but has noticed a 2.2 kg (5 lb) weight loss in the last month. He has no recent history of travel. Past medical history is unremarkable. On cardiopulmonary examination, bilateral velcro-like crackles are auscultated in the upper to middle lung fields, with normal heart sounds. There is a 3 x 3 cm swelling on the right shoulder with a normal range of motion and intact sensation. 5/5 muscular strength in all extremities is noted. Chest X-ray reveals bilateral nodular opacities in the upper lung lobes and a lytic lesion on the right humeral head. Electron microscopy of the lung biopsy shows the following. Which of the following is the most likely diagnosis?

A 19-year-old man comes to the physician for evaluation of night sweats, pruritus, and enlarging masses in his right axilla and supraclavicular area for 2 weeks. Physical examination shows painless, rubbery lymphadenopathy in the right axillary, supraclavicular, and submental regions. An excisional biopsy of an axillary node is performed. If present, which of the following features would be most concerning for a neoplastic process?
A 62-year-old man seeks evaluation at a local walk-in clinic for mid-low back pain of several weeks. He has tried different rehabilitation therapies and medications with no improvement. He was prescribed some pain medications and sent home last week, but the patient presents today with difficulty walking and worsening of his back pain. He was referred to the ER, where he was examined and found to have hypoesthesia from T12 to S4–S5, significant muscle weakness in both lower limbs, and reduced knee and ankle deep tendon reflexes. A hypotonic anal sphincter with conserved deep anal pressure was demonstrated on digital rectal examination, as well as a multinodular, asymmetric prostate. Imaging studies showed multiple sclerotic bone lesions along the spine. Subsequently, a prostate core biopsy was obtained which confirmed the diagnosis of prostate cancer. Which of the following characteristics would you expect in the specimen?
A 62-year-old man comes to the physician because of easy bruising and recurrent nosebleeds over the past 4 months. During the same time period, the patient has felt weak and has had a 10-kg (22-lb) weight loss. Physical examination shows mucosal pallor and bruising on the upper and lower extremities in various stages of healing. The spleen is palpated 4 cm below the left costal margin. Laboratory studies show anemia and thrombocytopenia. A photomicrograph of a peripheral blood smear is shown. Histologic examination of a bone marrow biopsy in this patient is most likely to show which of the following findings?
An otherwise healthy 66-year-old man comes to the physician for evaluation of rough skin over his forehead and the back of his hands. He has tried applying different types of moisturizers with no improvement. He has worked on a farm all his life. Physical examination shows two erythematous papules with a gritty texture and central scale over the left temple and three similar lesions over the dorsum of his hands. This patient's skin lesions increase his risk of developing a skin condition characterized by which of the following findings on histopathology?
A 62-year-old woman presents to the clinic for a 2-month history of ‘fogginess’. She reports that for the last couple of months she feels like she has "lost a step" in her ability to think clearly, often forgetting where she parked her car or to lock the front door after leaving the house. She also feels that her mood has been low. On further questioning, she reports mild constipation and that she has had a bothersome, progressively worsening cough over the past couple of months, accompanied by 6.8 kg (15 lb) unintentional weight loss. She has a history of hypertension for which she takes amlodipine daily. She has smoked 1.5 packs of cigarettes per day for the last 40 years. Physical exam is unremarkable. Laboratory studies show: Na+ 138 mg/dL K+ 3.9 mg/dL Cl- 101 mg/dL HCO3- 24 mg/dL BUN 10 mg/dL Cr 0.6 mg/dL Glucose 86 mg/dL Ca2+ 13.6 mg/dL Mg2+ 1.9 mg/dL Parathyroid hormone (PTH) 2 pg/mL (10–65) 1,25-hydroxyvitamin D 15 pg/mL (20–45) Quantiferon-gold negative Which of the following best describes this patient's most likely underlying pathology?
Characteristics of benign vs malignant tumors
Practice Questions
Nomenclature of neoplasms
Practice Questions
Carcinogenesis models
Practice Questions
Oncogenes and proto-oncogenes
Practice Questions
Tumor suppressor genes
Practice Questions
DNA repair genes and cancer
Practice Questions
Epigenetic mechanisms in cancer
Practice Questions
Apoptosis and cancer
Practice Questions
Tumor angiogenesis
Practice Questions
Tumor invasion and metastasis
Practice Questions
Carcinogenic agents
Practice Questions
Paraneoplastic syndromes
Practice Questions
Tumor immunology
Practice Questions
Get full access to all questions, explanations, and performance tracking.
Scan to download app
Enter your email to get your 85% OFF code and unlock the full USMLE question bank on the app.